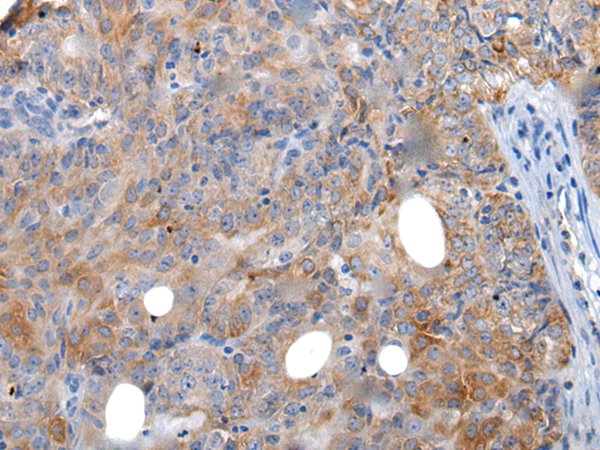

|
Background: |
This gene encodes an extracellular matrix protein with a spatially and temporally restricted tissue distribution. This protein is homohexameric with disulfide-linked subunits, and contains multiple EGF-like and fibronectin type-III domains. It is implicated in guidance of migrating neurons as well as axons during development, synaptic plasticity, and neuronal regeneration. |
|
Applications: |
ELISA, IHC |
|
Name of antibody: |
TNC |
|
Immunogen: |
Synthetic peptide of human TNC |
|
Full name: |
tenascin C |
|
Synonyms: |
GP; JI; TN; HXB; GMEM; TN-C; DFNA56; 150-225 |
|
SwissProt: |
P24821 |
|
ELISA Recommended dilution: |
5000-10000 |
|
IHC positive control: |
Human ovarian cancer and human cervical cancer |
|
IHC Recommend dilution: |
25-100 |

購物車
購物車 幫助
幫助
 021-54845833/15800441009
021-54845833/15800441009
